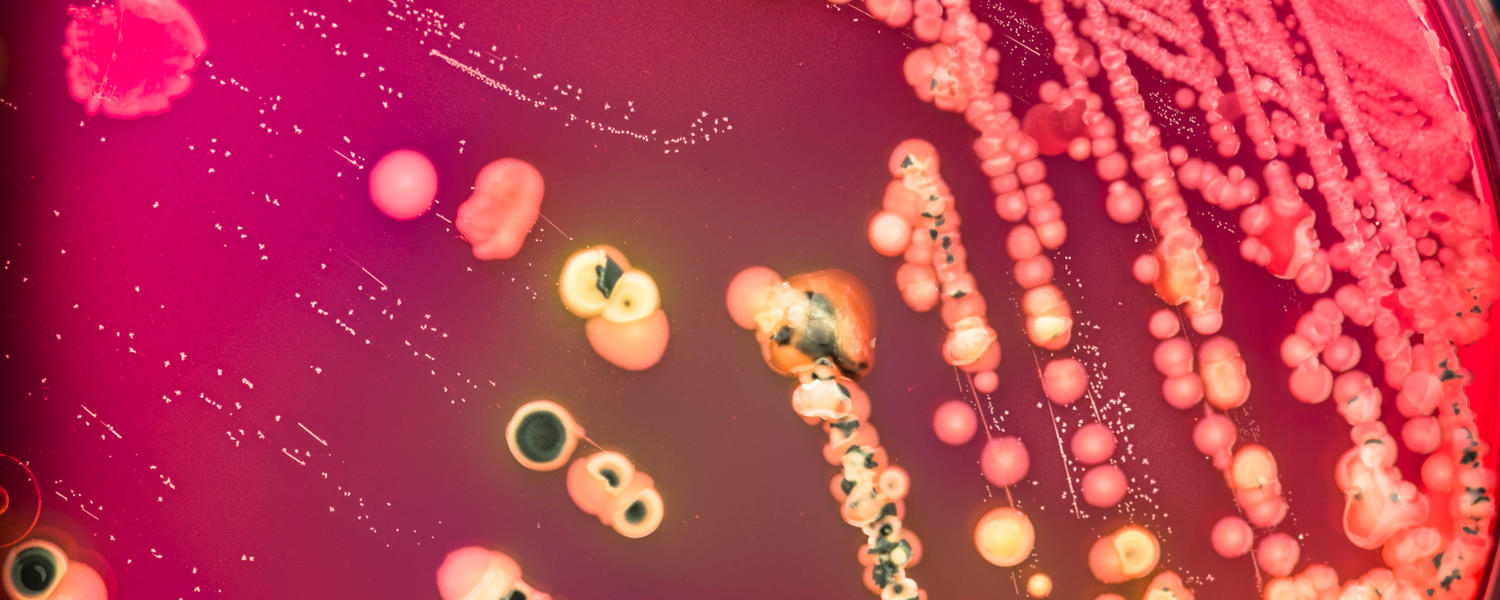

Biocomputing Group
Using computer simulations to study biological problems
Welcome to Peter Tieleman's Biocomputing Group
We create state-of-the-art computational models of lipids and membrane proteins to study their structure and dynamics, observe how they interact with each other, and gain a better understanding of the processes that occur at the molecular level of detail.